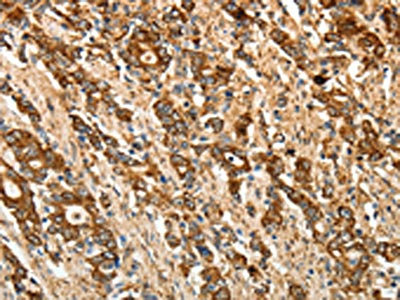

-
中文名稱:CALR兔多克隆抗體
-
貨號:CSB-PA314121
-
規格:¥1100
-
圖片:
-
The image on the left is immunohistochemistry of paraffin-embedded Human gastic cancer tissue using CSB-PA314121(CALR Antibody) at dilution 1/50, on the right is treated with fusion protein. (Original magnification: ×200)
-
The image on the left is immunohistochemistry of paraffin-embedded Human ovarian cancer tissue using CSB-PA314121(CALR Antibody) at dilution 1/50, on the right is treated with fusion protein. (Original magnification: ×200)
-
Gel: 10%SDS-PAGE, Lysate: 40 μg, Lane: NIH/3T3 cells, Primary antibody: CSB-PA314121(CALR Antibody) at dilution 1/800, Secondary antibody: Goat anti rabbit IgG at 1/8000 dilution, Exposure time: 3 seconds
-
-
其他:
產品詳情
-
Uniprot No.:
-
基因名:
-
別名:Autoantigen RO antibody; CALR antibody; CALR protein antibody; CALR_HUMAN antibody; Calregulin antibody; Calreticulin antibody; cC1qR antibody; CRP55 antibody; CRT antibody; CRTC antibody; Endoplasmic reticulum resident protein 60 antibody; Epididymis secretory sperm binding protein Li 99n antibody; ERp60 antibody; FLJ26680 antibody; grp60 antibody; HACBP antibody; HEL S 99n antibody; RO antibody; Sicca syndrome antigen A (autoantigen Ro; calreticulin) antibody; Sicca syndrome antigen A antibody; SSA antibody
-
宿主:Rabbit
-
反應種屬:Human,Mouse,Rat
-
免疫原:Fusion protein of Human CALR
-
免疫原種屬:Homo sapiens (Human)
-
標記方式:Non-conjugated
-
抗體亞型:IgG
-
純化方式:Antigen affinity purification
-
濃度:It differs from different batches. Please contact us to confirm it.
-
保存緩沖液:-20°C, pH7.4 PBS, 0.05% NaN3, 40% Glycerol
-
產品提供形式:Liquid
-
應用范圍:ELISA,WB,IHC
-
推薦稀釋比:
Application Recommended Dilution ELISA 1:2000-1:10000 WB 1:1000-1:5000 IHC 1:50-1:200 -
Protocols:
-
儲存條件:Upon receipt, store at -20°C or -80°C. Avoid repeated freeze.
-
貨期:Basically, we can dispatch the products out in 1-3 working days after receiving your orders. Delivery time maybe differs from different purchasing way or location, please kindly consult your local distributors for specific delivery time.
-
用途:For Research Use Only. Not for use in diagnostic or therapeutic procedures.
相關產品
靶點詳情
-
功能:Calcium-binding chaperone that promotes folding, oligomeric assembly and quality control in the endoplasmic reticulum (ER) via the calreticulin/calnexin cycle. This lectin interacts transiently with almost all of the monoglucosylated glycoproteins that are synthesized in the ER. Interacts with the DNA-binding domain of NR3C1 and mediates its nuclear export. Involved in maternal gene expression regulation. May participate in oocyte maturation via the regulation of calcium homeostasis. Present in the cortical granules of non-activated oocytes, is exocytosed during the cortical reaction in response to oocyte activation and might participate in the block to polyspermy.
-
基因功能參考文獻:
- unwanted cells such as aging neutrophils and living cancer cells are susceptible to "labeling" by secreted calreticulin (CRT) from macrophages, enabling their clearance through programmed cell removal. PMID: 30097573
- Patients with CALR mutation had significantly higher concentration of PDGF-BB and lower concentration of SDF-1alpha than patients with JAK2V617F mutation. High concentration of PDGF-BB and low concentration of SDF-1alpha in patients with CALR(+) ET may indicate a contribution of these chemokines in disturbed Ca2+ metabolism in platelets. PMID: 29390868
- These results implicate miR-455 regulated hydrogen sulfide protection of lung epithelial cells against hypoxia-induced apoptosis by stimulating Calr PMID: 30193773
- Calreticulin has a dual nature, and it has been found to be up-regulated or down-regulated in several types of cancer serving as either oncogene or anti-oncogene. PMID: 30444198
- Study propose that leukocytes infiltration via the binding of CRT to ITGAs is necessary for the onset and development of the ulcerative colitis and the inhibition of this interaction may be a novel therapeutic strategy for the treatment of inflammatory bowel diseases. PMID: 29773794
- Triplex probe-based TaqMan qPCR is an accurate and sensitive method for screening essential thrombocythemia or primary myelofibrosis patients with type I and II mutations in CALR. PMID: 30080988
- Comprehensive genomic characterization identified distinct genetic subgroups and provided a classification of myeloproliferative neoplasms on the basis of causal biologic mechanisms. Mutations in JAK2, CALR, or MPL being the sole abnormality in 45% of the patients. PMID: 30304655
- The prevalence of CALR mutation in JAK2V617F-negative essential thrombocythemia in this study is 35.7%. HRM is an effective method of detecting CALR mutation and is a more advantageous method of screening for CALR mutation. PMID: 29521158
- MPL and CALR genotypes show a similar clinical picture at essential thrombocythaemia diagnosis. In CALR genotype features of prefibrotic myelofibrosis are common. PMID: 29934356
- explored CRT reactivity of 14 different recombinant monoclonal antibodies (mAbs) derived from CLL patients carrying BCRs from various different stereotyped subsets PMID: 28751563
- The novel mutations occurred and changed the amino acid sequence of the C domain amino acid residues of CALR, which will interfere with the calcium-binding capacity of the molecule. The CALR mutations will improve our understanding of the pathophysiology of myeloproliferative neoplasms. PMID: 28747287
- Our study shows that JAK2V617F leads to abnormal expression of numerous proteins at the membrane of circulating PV red blood cells, with overexpression of CALR and persistence of CANX PMID: 28385780
- In 94.9% of PV, 85.5% ET and 85.2% PMF, authors found mutations in JAK2, MPL or CALR. 74.9% carried JAK2V617F, 12.3% CALR mutations, 2.1% MPL mutations and 10.7% were triple negative. PMID: 28990497
- these data support the model that CALR-mutated essential thrombocythemia could be considered as a distinct disease entity from JAK2V617F-positive myeloproliferative neoplasms PMID: 29217833
- This phenotypic diversity is further emphasized by the following report of a patient with an isolated erythrocytosis, persistent for nearly twelve years, associated with a CALR exon 9 mutation PMID: 28711709
- CALR exon 9 mutation is associated with myeloproliferative neoplasms. PMID: 28411309
- Absence of CALR mutations in JAK2-negative polycythemia. PMID: 27758825
- In 136 patients with myelofibrosis and a median age of 58 years who underwent allogeneic stem cell transplantation (AHSCT) for molecular residual disease, the percentage of molecular clearance on day 100 was higher in CALR-mutated patients (92%) in comparison with MPL- (75%) and JAKV617F-mutated patients (67%). PMID: 28714945
- Mutational subtypes of CALR correlate with different clinical features in Japanese patients with myeloproliferative neoplasms. PMID: 29464483
- CALR mutations is associated with non-hepatosplenic extramedullary hematopoiesis(NHS-EMH) and may possibly contribute to the pathogenesis of primary myelofibrosis -associated NHS-EMH. PMID: 27315113
- This study demonstrated that two patients had a heterozygous CALR exon9 mutation locating outside the coding region and did not alter the amino acid sequence of this protein. PMID: 28625126
- Multivariate analysis adjusted for age, sex, follow-up period and hematological parameters confirmed that increased activated B cells were universally present in JAK2-mutated, CALR-mutated and triple-negative ET patients when compared to healthy adults. PMID: 28415571
- these results reveal proteome alterations in MPN granulocytes depending on the phenotype and genotype of patients, highlighting new oncogenic mechanisms associated with JAK2 mutations and overexpression of calreticulin PMID: 28314843
- CALR mutation is associated with Essential thrombocythemia. PMID: 28205126
- the CALR-mutant stem cell would achieve clonal dominance much faster than the JAK2-mutant one and confirm the model initially proposed in which the clonal evolution of CALR-mutant MPN appears to be mainly associated with a progressive expansion of a mutant heterozygous clone that eventually becomes fully dominant in the bone marrow. PMID: 28422716
- The present study detected expression of CRT in patients with osteosarcoma , in the non-metastasis group compared with the metastasis group, and in the chemotherapy group compared with the non-chemotherapy group. CONCLUSIONS: These results could indicate a brand-new biological marker which may be applied to estimate the features and prognosis of osteosarcoma. PMID: 28106543
- in molecularly annotated ET patients at diagnosis, JAK2-V617F patients have more circulating microparticles and higher MP-associated procoagulant activities than CALR-mutated and TN ET patients. PMID: 27247323
- results suggest that CALR exon 9 mutations hold promise as targets for cancer immune therapies; for example as targets for vaccines or adoptive cell therapies. In order to formally establish that the CALR mutations act as tumor antigens for immunotherapy, we are currently working to establish specific T-cell clones to show that such clones recognize target cells that endogenously express mutated CALR PMID: 27560107
- Report PCR clamping technique for detection of type 1 and type 2 mutations in CALR gene in myeloproliferative neoplasms. PMID: 28031530
- Late-stage inhibition of autophagy enhances calreticulin surface exposure in colonic tumor cells. PMID: 27825129
- JAK2 and CALR mutations have roles in patients with essential thrombocythemia PMID: 27486987
- Clinical features of JAK2V617F- or CALR-mutated essential thrombocythemia and primary myelofibrosis. PMID: 26994960
- Studies indicate there are two main types of calreticulin gene (CALR) mutants, type 1 and type 2, and there is evidence about their distinct clinical/prognostic implications. PMID: 27384487
- our data suggest the involvement of autoimmune reactivity to CRT in a subset of patients suffering from DCM or HCM. PMID: 27689957
- Endoplasmic reticulum chaperone CRT plays a regulatory role in the invasion of EVTs, suggesting the importance of CRT expression in placental development during early pregnancy. PMID: 28938427
- findings demonstrate the potency of CALR mutants to drive expression of megakaryocytic differentiation markers such as NF-E2 and CD41 as well as Mpl. Furthermore, CALR mutants undergo accelerated protein degradation that involves the secretory pathway and/or protein glycosylation. PMID: 27177927
- Essential Thrombocythemia and Primary Myelofibrosis patients with CALR mutations are at high risk for Thrombotic Events. PMID: 28766534
- These findings showed that mutant CALR activates jak-stat signaling through an mpl-dependent mechanism to mediate pathogenic thrombopoiesis in zebrafish, and illustrated that the signaling machinery related to mutant CALR tumorigenesis are conserved between human and zebrafish. PMID: 27716741
- The present work suggests that Ca(2+)-dependent regulation is caused by different conformations of a long proline-rich loop that changes the accessibility to the peptide/lectin-binding site. Our results indicate that the binding of Ca(2+) to calreticulin may thus not only just be a question of Ca(2+) storage but is likely to have an impact on the chaperone activity. PMID: 27195812
- CRT regulates TGF-beta1-induced-EMT through modulating Smad signaling PMID: 28778674
- Our results showed that a wide range of different CALR mutations are associated with a distinct ET clinical phenotype that is associated with the male gender, younger age at diagnosis, higher platelet and lower leukocyte and erythrocyte counts and lower hemoglobin level, and a milder clinical course. PMID: 27521277
- alpha-Integrin expression and function modulates presentation of cell surface calreticulin. PMID: 27310876
- Although CALR mutations resulted in protein instability and proteosomal degradation, mutant CALR was able to enhance megakaryopoiesis and pro-platelet production from human CD34(+) progenitors. PMID: 27740635
- Studies show that all CALR mutations generate frameshift mutation in the exon 9, which encodes the C-terminus end conferring a common mutant-specific sequence in all mutants. Mutant CALR constitutively activates MPL to induce cellular transformation. The interaction between the mutant CALR and MPL is achieved by the conformational change in the C-terminal allowing N-domain binding to MPL. [review] PMID: 28741795
- C-CALR in response to Ca2+ undergoes conformational changes that trigger its function to export GR from the nucleus, resetting the stress response of normal erythroid cells. Impairment of this function in JAK2V617F-positive erythroid cells maintains EPO-R signaling in proliferation mode, contributing to erythrocytosis in PV. PMID: 28232234
- Mannan-binding lectin (MBL) bound to T cells through interaction between the collagen-like region of MBL and calreticulin (CRT) expressed on the T-cell surface. PMID: 28209773
- CRT exposure represents a novel powerful prognostic biomarker for patients with acute myeloid leukemia. PMID: 27802968
- In absence of CALR, immature MPO protein precursors are degraded in the proteasome. PMID: 27013444
- In patients with HD, a panel using calretinin and peripherin with or without MAP-2 may be most helpful in identifying transition zones PMID: 26469323
- Coexisting mutations of the JAK2, CALR, and MPL genes in myeloproliferative neoplasms suggest that CALR and MPL should be analyzed not only in JAK2-negative patients but also in low V617F mutation patients. PMID: 27855276
顯示更多
收起更多
-
亞細胞定位:Endoplasmic reticulum lumen. Cytoplasm, cytosol. Secreted, extracellular space, extracellular matrix. Cell surface. Sarcoplasmic reticulum lumen. Cytoplasmic vesicle, secretory vesicle, Cortical granule. Cytolytic granule.
-
蛋白家族:Calreticulin family
-
數據庫鏈接:
Most popular with customers
-
-
YWHAB Recombinant Monoclonal Antibody
Applications: ELISA, WB, IHC, IF, FC
Species Reactivity: Human, Mouse, Rat
-
-
-
-
-
-